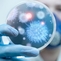

O número de pessoas curadas do coronavírus avançou mais de 100 mil em menos de uma semana, à medida que mais países vão vendo suas taxas de mortalidade em razão da pandemia diminuírem.
Após a China, a Espanha também está vendo sua taxa de mortalidade baixar. No último sábado (11), o país registrou o menor número de óbitos desde 23 de março e o governo espanhol estabeleceu as diretrizes para as pessoas que vão retornar ao trabalho em meio à flexibilização das medidas de confinamento.
Segundo dados atualizados pela Universidade Johns Hopkins neste domingo (12), o número total de curados do coronavírus em todo o mundo é de 411.836.
A China, país onde o vírus surgiu no fim de dezembro, segue a líder em números de cura, com mais de 77.953 pessoas recuperadas. Em seguida, aparece a Espanha, com 62.391 curados; Alemanha, com 57.400 mil e o Irã, com pouco mais de 43.894.
No Brasil, até o momento, 173 pessoas foram curadas, segundo o monitoramento em tempo real feito pela universidade. No total, 20.964 casos de infecção e 1.141 óbitos foram registrados no país.